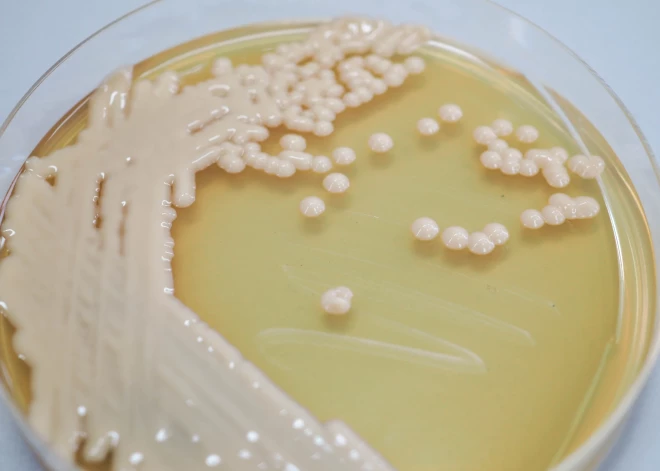
PVO pirmo reizi publicē sēnīšu sarakstu, kas rada nopietnus draudus sabiedrības veselībai

PVO pirmo reizi publicē sēnīšu sarakstu, kas rada nopietnus draudus sabiedrības veselībai
Pasaules Veselības organizācija ir publicējusi pirmo sarakstu, kurā iekļautas nāvējošas sēnīšu infekcijas, kas rada draudus sabiedrības veselībai.
Eksperti ir novērojuši, ka pieaug mirušo skaits no sēnīšu izraisītām slimībām, jo pret zālēm rezistentas bakteriālas infekcijas šobrīd izraisa aptuveni 1,27 miljonus nāves gadījumu gadā.
"Sēnīšu patogēni ir liels drauds sabiedrības veselībai, jo tie kļūst arvien izplatītāki un izturīgāki pret ārstēšanu," norāda PVO. Šīs infekcijas var izplatīties pat slimnīcās.
Covid-19 pandēmijas laikā palielinājās saslimstība ar aspergilozi, kandidēmiju un mukormikozi. Tā ir sēnīšu ierosināta saslimšana, kas skar pacienta seju un smadzenes un ir ļoti grūti ārstējama. Pazīstama arī kā “melnā sēnīte”. Covid laikā ar to īpaši smagi slimoja Indijā, un tiek uzskatīts, ka to varēja veicināt pārmērīga steroīdu lietošana, ko izmantoja smagas Covid-19 slimības gaitas ārstēšanai.
Minētie sēnīšu infekciju veidi bieži skar smagi slimus pacientus un pacientus ar nozīmīgām imūnsistēmas problēmām. Vislielākajam riskam ir pakļauti cilvēki ar vēzi, HIV vai AIDS, orgānu transplantāciju, hroniskām elpceļu slimībām vai tuberkulozi.

"Baktēriju antimikrobiālās rezistences pandēmijas ēnā parādījušās sēnīšu infekcijas kļūst aizvien rezistentākas pret ārstēšanu, kļūstot par sabiedrības veselības problēmu visā pasaulē," teica PVO ģenerāldirektora vietnieks antimikrobiālās rezistences jautājumos Dr. Hanans Balhijs.
Jaunajā ziņojumā PVO brīdina, ka kvalitatīvas diagnostikas un ārstēšanas iespējas attiecībā uz šīm augošajām sēnīšu slimībām ir ierobežotas. Zāles bieži vien nav pieejamas valstīs ar zemiem un vidējiem ienākumiem, kā rezultātā palielinās iedzīvotāju mirstība.
PVO norādīja, ka slimnīcās ir īpaši grūti izskaust vienu nāvējošu sēnīšu ierosinātāju - Candida auris, kas ir rezistents pret vairākiem medikamentiem, pat ar intensīviem infekciju profilakses pasākumiem.
Tas nozīmē, ka, konstatējot Candida auris, slimnīcu nodaļas bieži vien ir jāslēdz uz ilgāku laiku.








